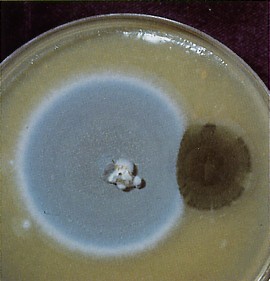
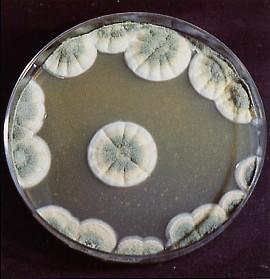

Kontaminace
- Kontaminace je velkým rizikem při pěstování hub, a proto se její eliminaci
musí věnovat maximum pozornosti!
- Naše kultury mohou být kontaminovány:
- spadem kontaminantů ze vzduchu, z hlavy, rukou a dalších částí těla při očkování bez ochranných pomůcek (viz Pomůcky)
- nedostatečně sterilizovanými nástroji
- nedostatečně sterilizovaným mediem a substrátem
- z otisku spor, ve kterém se nachází kontaminanty
- Během mých pěstebních pokusů jsem zjistil, že převážná většina (někdy i 100 %) kontaminací pochází z nedostatečně sterilizovaných nástrojů a substrátu. Substrát (obilky ječmene) bývá silně napadem aniž bychom o tom věděli. Na základě pokusů a srovnání několika metod jsem vypracoval postup, který je popsán v sekci Sterilizace.
- Nejčastěji bývají kultury napadány Penicilliem, Trichodermou, Aspergillem a Bacillem.
PENICILLIUM

náčrt struktury, která tvoří spory a charakterizuje penicilinovou plíseň
Třída
- Nižší houby
Řád
- Moniliales
Čeleď
- Eurotiaceae
Běžné jméno
- modrozelená plíseň
Latinský původ
- z „penicillum“ znamenající podobný štětci (chomáči vlasů), tak je pojmenována struktura tvořící spory
Vzhled a četnost výskytu
- extrémně běžná kontaminace, ačkoliv v přírodě není tak obvyklá jako venkovní Cladosporium
- Penicillium je nejvíce převládající vnitřní kontaminace a je nepochybně spojena s lidskými stravovacími návyky
- druhy Penicillium se hojně vyskytují na potravinách, stejně tak na ovoci, sýrech a uskladněném obilí
- mnoho druhů dává přednost kyselému pH
- Penicillium se příležitostně až často vidí na nedostatečně fermentovaném houbovém kompostu, krycí zemině a na rozkládajících se houbových zbytcích
Médium, kterým se kontaminace šíří
- primárně vzduchem
- rovněž uskladněným obilím a dalšími potravinami
- stejně tak jsou nejčastějšími nositeli této plísně lidé
Způsob ochrany
- filtrace vzduchu
- odstraňováním odpadních produktů
- izolací kontaminovaných kultur
- udržováním vysoké hygienické čistoty
Makroskopický vzhled
- objevuje se jako granulovaná nebo prášková modrozelená plíseň, často s širokým, bílým okrajem nového růstu
- některé druhy jsou méně viděny, jsou bílé, žluté nebo dokonce červené barvy
- mnoho druhů vylučuje na povrchu kapky tekutiny, která má antibiotické účinky
Mikroskopická charakteristika
- Konidiofory vybíhají jednotlivě, jsou dlouhé a blízko vrcholu se větví do krátkých řetězců kuliček zelených suchých konidií. v porovnání s houbovými sporami, konidie penicillia měří pouze 2—4 µm v průměru.
Historie, u ití a/nebo lékařské poznatky
- V 1928—1929, když Dr. Alexandr Fleming studoval Staphylococcus aureus, popsal, že kontaminace zelené plísně v její blízkosti zabránila v růstu kulturám bakterií. Tekutina, která byla vylučována houbou, vzbudila jeho zvědavost. Po publikování jeho objevu kolegové později objevili tekutinu, obsahující silné nové antibiotikum, které bylo pojmenováno Penicilin. v tomto případě se jednalo o Penicillium notatum Westl.
- Běžný penicilin se komerčně vyrábí z vysoce úrodných kmenů Penicillium Chrysogenum. Jeho u íváním byly vyléčeny miliony lidí z nemocí, které byly dříve neléčitelné. Po širokém rozšíření a zneužívání této drogy se vyvinuly nové nakažlivější a vůči penicilinu odolnější kmeny bakterií.
- Od produkce steroidů až po výrobu sýra Roquefort ( plísní penicillium roquefortii), je tento rod největším přínosem pro lidstvo. Pouze několik z nich je patogenických.
Poznámky
- pokud ve vnitřním prostředí převládá vysoký počet Penicillium spor, lze tuto kontaminaci omezit prostým dodržováním dobrých hygienických návyků
- Penicillium hojně tvoří spory a je to všudypřítomná houba
- v laboratoří je to nejběžněji viděná kontaminace
- ačkoliv Penicillium může napadat kompost, krycí zeminu a houbové zbytky, nevyskytuje se tak obvykle jako Trichoderma (jiné zelené plísně podobného vzhledu jsou Cladosporium a Aspergillus)
- obilná zrna kolonizovaná houbovým myceliem se stávají náchylnější k plísním, jako jsou Penicillium a Doratomyces, a šíří se do kompostu a/nebo krycí zeminy
- odlišnost tvaru Aspergillus a Trichoderma je v tvaru konidiofor
Další studijní informace
- „The Penicillia“ Rapera a Thoma (1949), kteří rozpoznali 138 druhů v době vydání publikace

Snímek z elektrónového mikroskopu Penicillium
TRICHODERMA

náčrt typické struktury Trichodermy tvořící konidia a spory
Třída
- Nižší houby
Řád
- Moniliales
Čeleď
- Moniliaceae
Běžná pojmenování
- lesnězelená plíseň
- zelená plíseň
- trichodermní skvrnitost
Řecký původ
- Spojením „trichos“ znamenající vlasatý a „derma“ znamenající kůže.
Vzhled a četnost výskytu
- velice běžná na kompostu, krycí zemině a v menší míře na obilí a agaru
- Trichoderma často parazituje na houbách po kultivaci a může zabránit jejich růstu, nebo ho omezit
- mnoho druhů roste na dřevě nebo dřevité tkáni a hojně se vyskytuje v rašelině
- Trichoderma roste často na dřevěných bednách pro substrát
Médium, kterým se kontaminace šíří
- primárně vzdušná kontaminace, která kontaminuje agar nebo obilné kultury
- sekundárně kontaminuje krycí zeminou, rašelinou nebo humusem.
- Trichoderma se často šíří během sklizně
- druhy tohoto rodu obvykle upřednostňují kyselé pH od 4—5,5 (6)
Způsob ochrany
- opatrným sběrem
- odstraňováním uhynulých a nemocných plodnic
- snižováním vlhkosti
- snižováním oxidu uhličitého a zvýšená cirkulace vzduchu eliminuje stojící vzduchové kapsy
- používáním čistých krycích materiálů bez rozkládající se dřevné hmoty se sníží šance kontaminace Trichodermy
- izolace rozvinuté Trichodermy může být snadno dosaženo jednou z některých metod
- Trichodermě se daří v kyselém prostředí, zvýšení pH okolní půdy zabrání dalšímu růstu
- snad nejjednodušší cestou zvýšení pH je posypání infikované kolonie solí, nebo sodou bikarbonou (jedlou sodou) nebo jejich roztokem
- rozpoznání a eliminace této houby v jejich nejčasnějších stadiích, předtím než jsou vytvářeny spory, hodně snižuje riziko dalšího rozšíření satelitních kolonií v pěstební k ji
- houby napadené Trichodermou by měly být opatrně izolovány
- všechny věci, které s ní přišly do kontaktu (nástroje, oděv etc.), by měly být ošetřeny
- spory této houby zahubí parní pasterizace při teplotě 70 °C po dobu jedné hodiny
Makroskopický vzhled
- bavlněná plíseň, rostoucí v kruhových koloniích na krycí zemině nebo na kompostu; zpočátku našedlá a rozptýlená; rychle rostoucí; brzy od produkce spor lesnězelená
- na sladovém agaru mají kolonie Trichodermy vzdušné, bavlněné a lesklé lesnězelené mycelium, zatímco Penicillium je bělavé nebo nažloutlé, ale hlavně ty, které jsou vidět v houbových kulturách, jsou nazelenalé
- napadené houby mají suché hnědé skvrny nebo poškození na klobouku nebo třeni
- často jsou pokryty jemným práškovým pudrem, který může eventuálně dostat zelenou barvu od produkce spor, silně deformované
Mikroskopická charakteristika
- průhledné konidiofory, souměrně rozvětvené, na jejichž koncích jsou malé oválné chomáčky hladkých oválných spor s nazelenalým nádechem
- u mnoha druhů se vyskytují originálně tvarované sporogenní buňky, vzdáleně se podobají kulovým hlavičkám uspořádaným do triád
- po rozmačkání vzorku pro pozorování konidiofor pod mikroskopem jsou málokdy viditelné a obtížně identifikovatelné
- volná konidia nejsou uspořádána do přímočarých řetězců, jak je běžně vidět u Aspergillus a Penicillium, ale jsou ve volných klastrech nebo jsou individuálně roztroušena
- nejlepším rozlišovacím znakem je to, že konidia jsou obklopena substancí podobnou hlenu, obsahující lepkavé spory měřící 3—5 x 3—4 µm
Historie, u ití a/nebo lékařské poznatky
- patogenita není známa
- jedna průmyslová aplikace využívá Trichodermu, Penicillium a Cladosporium k získávání kovů z roztoku, jako je zlato a platina (tento proces je patentován)
Poznámky
- Na pokryté obilné kultuře je Trichoderma nejčastěji se vyskytující kontaminace krycí zeminy a obvykle z ní i pochází. Po pokrytí přechovávané spory z rašeliny infikují obilná zrna a vytvářejí spory. Kontaminovaná zrna se stávají nástupištěm pro další kontaminace. Plíseň se poté šíří krycí zeminou, pokud neproroste plochou krycí vrstvy. Trichoderma se tvoří v zemině s nerozloženou dřevní hmotou a také s přítomnou jílovou zeminu. Kontaminace Trichodermou je také zapříčiněna nadměrným přemokřením krycí zeminy, která je aplikována na sterilní obilné podhoubí.
- Trichoderma je všudypřítomná houba, která je povzbuzována nesprávně nastavenými parametry prostředí. Pro tuto kontaminaci jsou příznivé podmínky nadměrně vysoké a prodloužené vlhkosti v kombinaci se stojícím vzduchem a vysokou úrovní oxidu uhličitého a nevyvážená krycí zemina. Pokud se populace Trichodermy rozmnoží, plíseň rychle infikuje nově vytvářená primordia a vyvíjející se plodnice, které se začnou deformovat. Tento patogen roste také na vyhozených houbových zbytcích a částečně na třeních.
- Napadené houby mají hnědé skvrny nebo poškozené třeně, zvláště blízko báze nebo u vrcholu. Chmýřovité mycelium podobné Verticillium může být přítomno i na klobouku. Tato poškození jsou suchá, zatímco skvrny způsobené bakteriemi mají tendenci mokvat. Růst plodnic se touto plísní prudce zastavuje. v extrémních podmínkách tato plíseň vytváří přímo na houbách, které mají zelenou barvu. Sousední plodnice, nově vytvořené kloboučky a následná sklizeň se zachrání, jestliže se zvýší cirkulace vzduchu na přiměřenou úroveň a jestliže se sníží vlhkost na tolerovatelnou mez (3—5 vzduchových výměn za hodinu a udržování 85—92% vlhkosti). Trichoderma pravděpodobně vylučuje toxiny, které brání tvorbě houbových primordií a jejich růstu.
- Další problém s Trichodermou tkví v tom, že její spory slouží jako potrava červených roztočů. Spory Trichodermy jsou lepkavé a přilnou ke všemu, co s nimi přijde do styku. Roztoči a další přenašeči šíří trichodermní kontaminaci právě touto cestou. Brzy po propuknutí Trichodermy není neobvyklé vidět populační explozi roztočů.
- Nejpozoruhodnější jsou Trichoderma viride (synonymum Trichoderma lignorum), brzy se objevující plíseň s hrubými sporami, a Trichoderma koningii, rovněž sporová plíseň viděna později v pěstebním cyklu. Obě jsou pro houby patogeny.

ASPERGILLUS

náčrt charakteristické struktury Aspergillus tvořící spory
Třída
- Nižší houby
Řád
- Moniliales
Čeleď
- Eurotiaceae
Běžná pojmenování
- zelená plíseň
- žlutá plíseň
- černá plíseň
Latinský původ
- z „aspergilliformis“, což znamená štětcového tvaru, poukazuje na tvar konidiofor
Vzhled a četnost výskytu
- velmi běžný na agaru, obilné kultuře i při výrobě kompostu
- vyskytuje se na všech organických substrátech
- Aspergillus preferuje neutrální nebo slabě neutrální pH
Médium, kterým se kontaminace šíří
- Vzduchem
Způsob ochrany
- Dobré hygienické návyky
- odstraňování infikovaného substrátu, obzvláště zbytků potravy a vyplozeného kompostu
- filtrací vzduchu přes mikronové filtry
Makroskopický vzhled
- Barevný rozsah od luté přes zelenou až k erné.
- nejčastěji jsou druhy Aspergillus zelenkavé a podobné Penicillium
- Aspergillus niger, jak jeho jméno naznačuje, je černý
- Aspergillus flavus je žlutý
- Aspergillus clavatus je modrozelený
- Aspergillus fumigatus je šedozelený
- Aspergillus veriscolor vytváří různé barvy (zelené přes růžové až ke lutým)
- tyto plísně, jako mnoho dalších, mění barvu a vzhled podle média, na kterém se vyskytuje
- několik druhů je termofilních
Mikroskopická charakteristika
- struktura tvořící spory je vysoká, nevětvená, lodyze podobná, vytvářející na vrcholu kulovité hlavičky, na kterých jsou uspořádané přímočaré řetězce jednotlivých buněčných spor (konidií) měřící 3—5 mm
Historie, u ití a /nebo lékařské poznatky
- některé druhy jsou toxické
- Aspergillus flavus, žlutý až žlutozelený druh, produkuje smrtelné aflatoxiny
- Aspergillus flavus napadá moučku z bavlníkových semínek, oříšků a jiných semen s vysokým obsahem oleje, které byly skladovány v teplém a vlhkém prostředí
- ze všech biologických produkovaných toxinů jsou aflatoxiny nejnebezpečnější hepatakarcinogeny, které byly doposud nalezeny
- toxicita tohoto druhu byla donedávna neznámá, dokud v roce 1960 záhadně nezahynulo 100 000 krocanů při propuknutí této nemoci ve Velké Británii
- protože A. flavus roste prakticky na všech typech obilí, je tento druh vážným ohrožením výrobců podhoubí
- Aflatoxiny se nevyskytují v sebraných plodnicích, ačkoliv bylo použito kontaminované podhoubí nebo bavlníková moučka jako doplněk kompostu
- Aspergillus Fumigatus a Aspergillus niger, dva termofilní mezofily, jsou rovněž pro lidi v koncentrovaných množstvích patogenní. Postižení se nazývá Aspergiolisa nebo „Plicní onemocnění pěstitelů hub“. Nejčastějším zdrojem Aspergillus fumigatus je vyplozený kompost.
- Aspergillus niger, běžná černá plíseň, která byla vyšlechtěna komerčně, pro svoji schopnost syntetizovat kyselinu citrónovou a kyselinu gluconikovou z prostého sacharozového obohaceného roztoku. Dříve byla kyselina citronóvá extrahována z citrónové šťávy; nyní je účinněji vyráběna právě touto houbou.
Poznámky
- Jedná se o nebezpečný rod. Pokud existuje možnost, v kursech houbových kultur přijít do styku s Aspergillus Flavus, A. niger, A. fumigatus, měly by být u iněny předběžná opatření k minimalizaci nákazy těmito toxickými kontaminacemi.
- Aspergillus Candidus je krémově zbarvená plíseň, která kolonizuje obilí, jehož následkem je ostrý nárůst teploty podhoubí.
Další studijní informace
- „The Genus Aspergillus“ autorů Rapera a Fennela a monografie, ve které bylo rozpoznáno 132 druhů. Zanedlouho bude známo více než 200 druhů.

druhy Aspergillus jak jsou vidět přes světelný mikroskop

snímek z elektronového mikroskopu spor Aspergillus
BACILLUS

náčrt endospor, které vytvářejí buňky Bacillus, jak se jeví přes mikroskop
Čeleď
- Schizomycetes
Podruh
- Eubacteriales
Rod
- Bacillaceae
Běžné jméno
- mokrá skvrnitost
- mokrá hniloba
Latinský původ
- z „bacilliformis“, znamenající podobný tyčince, poukazuje na jeho charakteristický tvar
Vzhled a četnost výskytu
- tvoří širokou škálu tvarů
- Bacillus roste téměř na všech organických materiálech, které jsou vlhké a jsou obklopené kyslíkem
Médium, kterým se kontaminace šíří
- primárně vzduchem
- sekundárně vodou, obilím, zeminou, kompostem, hmyzem, nástroji a pracovníky
Způsob ochrany
- filtrací vzduchu vysoce efektivními částicovými vzduchovými filtry
- sterilizací obilí
- řádným uskladněním a používáním relativně „čistého“ obilí
- přídavek antibiotik k agarovému médiu (gentamycin sulfát, penicillin, streptomycin, auremycin, atd.) má bránit nebo ochraňovat před růstem kontaminací
- endospory jsou neutralizovány vystavením vlhkého tepla, které poskytuje pára tvořená v tlakovém hrnci při teplotě 120 °C, která usmrtí vegetativní rodičovské buňky, které již nebudou moci tvořit endospory
Makroskopický vzhled
- matně šedý podobný hnědému slizu, který je charakterizován silným kvasným zápachem, někdy popisován jako zápach hnijících jablek, špinavých ponožek nebo spálené slaniny
- Bacillus způsobuje to, že nekolonizované obílí vypadá nadměrně mokré, odtud pojmenování „mokrá hniloba“ (tuto kontaminaci dobře charakterizují šedobílé rýhy podél okrajů jednotlivých obilných zrn)
Mikroskopická charakteristika
- tyčinkového nebo cylindrického tvaru, měří 0,3—2,2 µm v průměru a 1,2—7,0 µm na délku
- pokud se pozoruje mokrý vzorek přes mikroskop, Bacilli se znatelně vrtí
- tento druh se přesouvá vibrováním bičíku „vlasu“, který pohání každou buňku
- bičíky jsou pod mikroskopem obtížně viditelné při použití klasických pozorovacích technik
- Bacilli jsou uzavřeny v tobolce s tenkým, ale pevným povlakem a konglomerace buněk vyvolává infekci obilí slizkého vzhledu
- Bacillus se primárně množí jednoduchým buněčným dělením
- V dobách nepříznivých podmínek prostředí, zvláště teplotních, se v každé rodičovské buňce vytvoří samostatné zatvrdlé spory (tyto endospory vykazují pozoruhodnou odolnost vůči teplu, mají nízký obsah vody a nepodléhají vysušení)
- druhy tohoto rodu mají pozitivní Gram test

Bacillus, bakterie mokré skvrnitosti, jak se jeví na obilí

snímek ze skenovacího elektronového mikroskopu, tyčinkové bakterie
na spoře Panaeolus acuminatus

snímek ze skenovacího elektronového mikroskopu tyčinkové bakterie na
myceliu Psilocybe cubensis
Historie, u ití a/nebo lékařské poznatky
- nejpozoruhodnější druh tohoto rodu je Bacillius anthracis, způsobující ošklivé antraxové onemocnění, které zabilo několik tisícovek ovcí, když s ním v 50. letech experimentovala armáda USA v Utahu
- domácí pěstitelé jsou pravděpodobně málo vystaveni tomuto druhu bakterií, protože většina endospor tvořících bakterie není nakažlivá
- Bacillus subtilis napadající obilné podhoubí poslouží k záměně E. coli jako rekombinačního DNA fermentoru
- Clostridium je podobný rod jako Bacillus s výjimkou toho, že je anaerobní. Tento rod má jeden obzvláště toxický druh: C. botulinum, který způsobuje botulismus.
Poznámky
- zhoubný a houževnatý konkurenční organismus
- kontaminace Bacillius se rozpoznává nejobtížněji
- Při pokojové teplotě se jednotlivé buňky množí každých 20 minut a budou znásobeny do téměř milionu dceřiných bakterií jen v sedmi hodinách. v dalších sedmi hodinách se každá z tohoto milionu bakterií rozdělí do dalšího milionu buněk. Takto se v méně jak 14 hodinách vyvine 1 trilion bakterií a to z jediné rodičovské buňky.
- Fenomenální reprodukční schopnosti Bacillus a jiných bakterií vytváří obrovskou hrozbu pro výrobce podhoubí. Ačkoliv rodičovské buňky jsou snadno zničeny, jejich endospory nikoliv. v suchých podmínkách se endospory tvoří ve zvýšeném počtu, dokud teplota nedosáhne 55 °C. Při teplotě varu vody (100 °C) se životaschopnost endospor markantně snižuje. (90 % spor Bacillus je zabito již v první minutě při teplotě 212 °F.) Při vyšší teplotě a tlaku v autoklávu přežívá méně než 1 % spor Bacillus. Nicméně i toto 1 % dokáže v obilné kultuře obnovit rychlé reprodukční schopnosti tohoto mikroorganismu. Tento problém je tím větší, čím vyšší je počáteční počet bakterií.
- V jedné studii (Sloupaná a Ernst, 1962) stanovil dobu termální smrti (TDT) u populace Bacillus Stearothemophilus složené z 13 000 000 endospor na 13 minut při teplotě 120 °C (V tlakovém hrnci v 0 nadmořské výšce, 120 °C odpovídá tlaku 15 psi).
- Výzkumy hygieniků s jídlem nakaženým bakteriemi (částečně Clostridium) ukázaly, že odolnost endospor vůči teplu je ve vztahu k množství vápníku v hostitelském substrátu.
- Jednou vytvořené endospory mohou zůstat v ivotaschopném stavu delší
dobu. Když byly přeneseny ze aludků mumií, byly životaschopné i po
stovkách let.
- Ačkoliv se v autoklávu může nastavit přesná teplota, obilí v nádobách
může setrvávat pod touto teplotou. K zajištění náležité parní penetrace,
by se voda v tlakovém hrnci před uzavřením tlakového ventilu měla
vařit po dobu 5 minut. Kromě toho jsou bakterie v nádobách s podhoubím
částečně chráněny před vlivem sterilizační páry strukturálními dutinami
obilného média. Ty brání parní penetraci, což se děje obzvláště u velkých
a plně zavezených autoklávů.
- Navzdory tomuto faktu, že sterilizace v autoklávu po dobu 1 hodiny při tlaku 15 psi je dostačující k zahubení většiny kontaminací, obilí mající vyšší počáteční bakteriální populaci může vyžadovat sterilizaci při vyšší teplotě a delším čase. Sterilizace 1l lahví po dobu 1 hodiny při teplotě 132 °C (je ekvivalentní jako při tlaku 27 psi) je dostatečná k neutralizaci obilí silně zasaženého endosporami, které tvoří bakterie. Když se předělává standardní domácí tlakový hrnec k tomuto účelu, kontaktovat výrobce o krajních mezích a dodržovat všechny bezpečnostní pokyny.
- Pokud se „sterilizované“ žito spontánně kontaminuje bakteriemi
ještě před očkováním, je nejlépe zaměnit je za čistější obilí, než opakovat
drahou a časově dvojnásobnou sterilizaci. Některé laboratoře vyrábějící
podhoubí obilí předvařují,to umisťují do nádob a ty pak sterilizují
ve standardním čase a tlaku.
- Nejpraktičtější metoda eliminace bakteriálních endospor obnáší namočení obilí do vody při pokojové teplotě a to 24 hodin před sterilizací. Endospory v tomto čase vyklíčí, pokud jsou životaschopné, a poté již následují standardní sterilizační procedury. Nové endospory se již nebudou moci tvořit ve vlhkém prostředí obilí uskladněného v lahvích.
- Bacillus subtilis var. mucoides je běžná bakterie odpovědná za zkažené
nosiče podhoubí. Jestliže se umožní její šíření, kontaminace zavleče nákazu
do laboratoře, což vyžaduje zcela uzavřít její provoz. Spory a podobné
kmeny houbového mycelia se mohou stát hostiteli Bacillus, ty pak přenášejí
bakterie na svých hyfách (viz obrázky výše) a poté kontaminují médium,
do kterého bylo houbové mycelium přeneseno.
- Mnoho bakterií je tyčinkového tvaru a termín Bacillus byl používán k jejich
pojmenování.
- Gen Bacillus je nyní definován jako Gram positivní tyčinková, aerobní
bakterie, která vytváří spory.